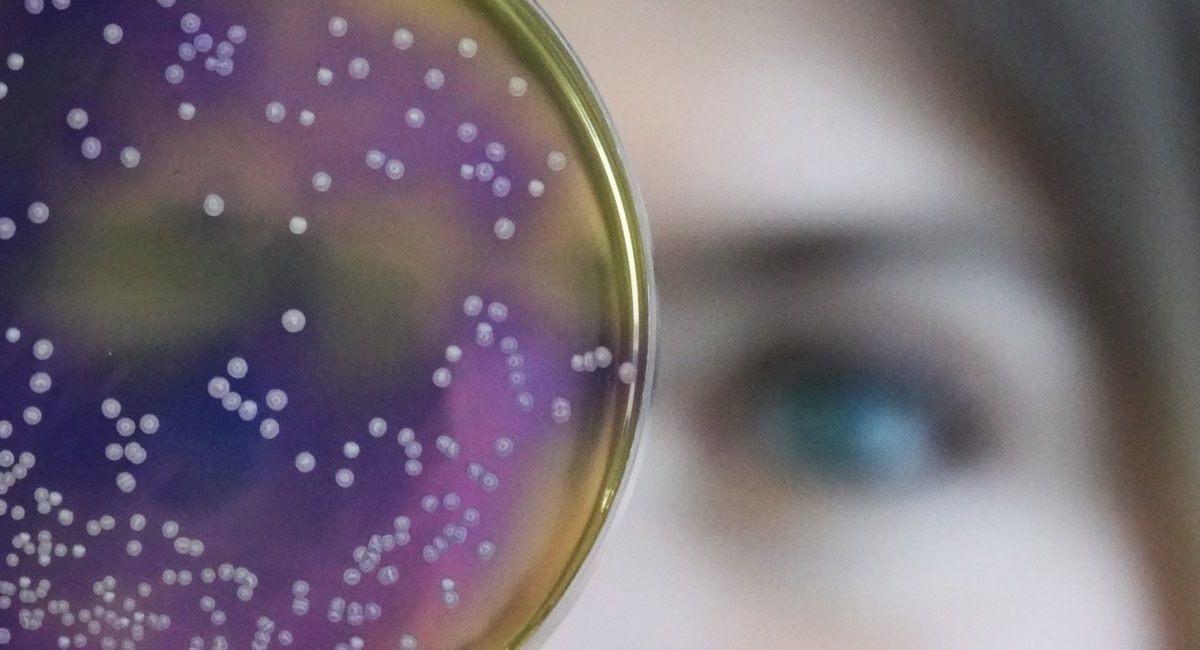
yeast cell colony humans

For any living organism, the recipe for success is simple: gather the resources that allow you to survive and thrive, avoid predators and toxic environments, and then reproduce in a fashion so that your offspring have a chance to survive and reproduce as well. From single-celled bacteria to complex and differentiated plants and animals, even though their metabolisms and living conditions are wildly different, that recipe is practically universal.
However, simply following that recipe, generation upon generation, can often lead to an unintended consequence: the depletion of necessary resources and the build-up of waste products that result from completed metabolic processes. Over long enough timescales or with large enough populations, this can transform a once-plentiful environment that possessed favorable conditions for that organism to survive and thrive into a resource-depleted, pollution-rich environment. This transformation renders that ecosystem, all of a sudden, uninhabitable to the organisms that have survived there for so long.
With more than 8 billion humans now inhabiting planet Earth, we’re at risk of doing precisely this to the one environment that unites us all: the biosphere of our world itself. Our long-term survival now hinges on our ability to act collectively for the good of our distant descendants. Otherwise, we’ll prove ourselves, in the end, no smarter than a simple colony of yeast cells, which routinely poison themselves to extinction if left to their own devices.

A yeast cell is a relatively advanced — at least, evolution-wise — microorganism that’s officially classified as a fungus. They are eukaryotic, meaning that unlike bacteria, they possess a cell nucleus and well-defined organelles: capable of carrying out various functions essential to their life processes. Yeast power their life processes through the gathering of a specific resource we’re all familiar with: carbohydrates, such as sugars, starches, and oligosaccharides. They metabolize those carbohydrates to obtain energy through the process of fermentation, which produces carbon dioxide and alcohols as a waste product.
While humanity has leveraged yeast for thousands of years to take advantage of these waste products — using the carbon dioxide bubbles as a leavening agent in cooking and baking and the alcohols for coping with the otherwise unbearable ennui of living as a human being — yeast cells themselves first arose many hundreds of millions of years ago: before mammals of any type were present on Earth. And although yeast cells can reproduce through a variety of mechanisms, the most frequent is by budding: where a parent yeast cell forms a small bud, then the nucleus begins to undergo mitosis, with the “copied” genetic information migrating into the bud until it grows sufficiently to separate from the original parent cell.

One experiment that many high school biology students perform is to simply:
- take a small sample of yeast cells,
- prepare a carbohydrate-rich liquid “broth” to serve as the environment,
- and place the yeast cells within it.
The next step in the experiment is simply to allow time to pass, and to regularly measure the population density of yeast cells by sampling a “drop” of the broth, placing it under a microscope, and counting the number of cells within a particular (small) volume of broth.
Early on, the results are precisely what one might expect: the population of yeast cells begins growing at an alarming, exponential rate. With copious nutrients and resources available, favorable temperature conditions, and no predators or competitors for resources, practically every yeast cell can survive, thrive, and reproduce. Because yeast cells can duplicate themselves every 90 minutes or so under these near-ideal conditions, their population, a scant 24 hours after first placing them in this nutrient-rich environment, can increase by a whopping factor of ~65,000: because there are 16 “doubling times” for yeast in every 24 hours, and 216 = 65,536.

However, if you return to your yeast cells after 48 hours, you won’t find that their population is now some ~4 billion times the original population, even though 48 hours have passed, enabling the passage of 32 “doubling times.” Yes, it’s true that 232 = 4,294,967,296, but by this point, the yeast cells have now grown so numerous for the environment they’re in — assuming you’re conducting your experiment in something like a petri dish and not a private lake — that resources are no longer abundant for the population of yeast cells that inhabit it. Not every yeast cell can survive, thrive, and reproduce, and so the population begins to level off and plateau.
However, as large populations of yeast continue to consume the carbohydrates in their environment, they produce now-substantial (for the size of their environment) amounts of waste products: alcohols and carbon dioxide. Because they’re in an aqueous environment, the carbon dioxide reacts with water to produce carbonic acid, which slowly begins to acidify the broth inhabited by the yeast. While this is actually slightly beneficial for a time (most yeast cells thrive in slightly acidic environments, more so than in pH neutral ones), the combined effects of:
- an (eventually) extremely acidic environment,
- an alcohol-rich environment,
- and a carbohydrate-poor (after overconsumption) environment,
lead to a crash in the yeast population.

In fact, as resources become scarce, some yeast cells have been discovered to actually release a toxin that they themselves can survive, but that other yeast cells — even of the same species and even clones of the same organism — will die when exposed to it. In other words, through a combination of simple, mindless consumption and the continuation of their life processes, yeast cells deplete the nutrients within the environment and poison it, making it less habitable for their offspring. Many of the surviving yeast cells, now in a nutrient-depleted environment, engage in some sort of intra-species warfare, hoping for their own individual survival at the cost of the survival of rival yeast cells.
As one might expect, continued monitoring of the yeast population shows that the exponential growth phase isn’t simply followed by a plateau phase, but then begins to fall off and decrease, dropping more severely and rapidly the higher the population peak was, until eventually there are no additional yeast cells remaining. Left unchecked, without a new niche to expand into or without some “purifying” event to detoxify and replenish the nutrients in their environment, the once-successful yeast population will soon go extinct: a victim of their own overconsumption and waste production.

This story isn’t unique to yeast cells in petri dishes, either. Somewhere between 3.5 and 2.7 billion years ago, the first cyanobacteria (also known as blue-green algae) evolved, eventually spreading to Earth’s oceans. These simple prokaryotic life forms don’t obtain energy from their environment by consuming carbohydrates, but rather through photosynthesis: where energetic light from the Sun strikes a photosynthetic pigment. That interaction sends the pigment molecule into an excited state, where its subsequent de-excitation can be used to:
- provide energy to be used immediately by the organism,
- or provide energy that can be stored, chemically, in the form of sugars, starches, or adenosine triphosphate (ATP),
- which produces a waste product that hasn’t existed in substantial quantities on Earth prior to this: molecular oxygen (O2).
Previously, Earth’s atmosphere was made mostly of nitrogen, carbon dioxide, water vapor, methane, and a bit of argon gas. However, as cyanobacteria continued to survive and thrive for hundreds of millions of years, they gradually began to transform Earth’s atmosphere by adding oxygen into the mix. As the oxygen accumulated, it oxidized surface minerals (like iron) and contributed to the decomposition of deceased life forms, but as the cyanobacteria continued to thrive and grow in population, they began to pollute Earth’s atmosphere with this new waste product: O2.

This time period, where oxygen was first produced in great abundance on Earth, is known as the Great Oxygenation Event, which eventually led to an incredible mass extinction that killed over 80% of living species on Earth. The reason for this? Most organisms living at that time were anaerobic in nature, and oxygen was toxic to those life forms. The methane in the atmosphere became oxidized, and eventually methane levels dropped to only trace amounts. The new atmosphere, with a reduced greenhouse effect, caused Earth’s temperature to drop, leading to a series of extreme glaciation events, and a condition known as “snowball Earth” where possibly the entire planet’s surface was covered in ices and snows.
The appearance of oxygen, which would become so essential to the later emergence of animals and human beings, came about only as a “useless” waste product that arose from photosynthesis. And yet, the unchecked production of oxygen wound up having a global effect that nearly murdered all living species on Earth.
This is a common theme among all mindless organisms: they continue to simply use their metabolism and undergo their life processes, and if that winds up destroying, polluting, or even poisoning the environments that they inhabit, that’s a consequence that every organism — including the polluting organism’s descendants — must reckon with.

As human beings, with over 8 billion of us on planet Earth at present, we now find ourselves in a very analogous situation to both the early cyanobacteria from over 2 billion years ago and the yeast cells one would culture within a nutrient-rich broth in a petri dish. It isn’t that we’re in danger of transforming our planet into an uninhabitable hellscape, as nothing we’ve done or are in the process of doing is going to have a catastrophic effect of that magnitude. However, there are a number of ways that we’re polluting, destroying, or depleting our environment in ways that not only are non-renewable and unsustainable, but that are going to have negative downstream effects that impact future humans, hundreds and even thousands of years down the line, in ways that most of us aren’t prepared to fully reckon with.
And that’s unfortunate, because we should be prepared. After all, unlike yeast, cyanobacteria, or any other species that’s impacted its environment due to its collective, accumulated actions, we can not only detect and quantify the effects we’re having, but can choose to change our action at any time. We’ve done this many times before, particularly during the 20th century, and were able to avert crises by:
- severely regulating pollution from the obtaining, refining, and burning of oil (1924),
- the banning of chemicals that contaminate drinking water (1935),
- the banning of chemicals that are hazardous to air-breathing life (1948),
- the banning of thalidomide (1962),
- the Clean Air act (1970),
- stronger controls on water pollution (1972) and drinking water safety standards (1974),
- the banning of polychlorinated biphenyls, or PCBs (1978),
and the severe reduction in chlorofluorocarbons, or CFCs, that created the now-healing hole in the ozone layer.

Today, however, we teeter on the brink of a number of crises.
Loss of wild habitats: only 23% of the planet’s non-Antarctic land and 13% of the ocean remain as wild habitats, free from the direct occupation of humans. (Less than a century ago, both of these numbers were over 50%.)
Climate change: between elevated CO2 concentrations due to human activities, global warming, weather destabilization, changes in the global water cycle, and ocean acidification, this crisis continues to worsen at a critical time for our ecological stability.
Oceanic exploitation: in addition to ocean acidification, human activities such as overfishing, deep-sea mining operations, plastic pollution, and widespread habitat destruction have been problems that went unaddressed (or under-addressed) for a very long time. Only days ago, on March 4, 2023, was the High Seas Treaty agreed to, and much like the Paris climate accord, requires voluntary international cooperation.
And the exploitation and pollution of Earth’s orbit and Earth’s night skies: where light pollution, the sky brightness from reflected satellite light, the damage to ground-based and space-based astronomy, atmospheric pollution from deorbiting satellites, and the risk of Kessler syndrome — rendering low-Earth orbit impassable and full of debris — remain real, worsening risks, as no meaningful regulation beyond the archaic Outer Space Treaty presently exists, and the number of active low-Earth orbiting satellites is projected to grow from its present number of ~3000 to more than ~60,000 over the next decade.

All of this brings us to the present moment: planet Earth in the year 2023. We have, realistically, only two options at this moment in time. We can decide to collectively address these problems — and yes, it will take collective action, as only a small number of reckless or unconcerned individuals can undo the good actions of billions of others — creating a positive long-term future for our distant descendants to enjoy, stemming the downstream effects of our present problems as much as possible without creating new or worsened ones. Or, alternatively, we can fail to address them, and instead of investing in the necessary “ounce of prevention,” can leave future generations, perhaps for hundreds or even thousands of years, to pay for the “pound of cure” over and over again.
The path we’ll choose, collectively, depends on what our species’ answer is to the titular question of this article: Is humanity dumber than a colony of yeast cells? Sure, if you go by the Doomsday Clock, it might seem like we’re already a lost cause, destined to drive ourselves over the edge of the cliff and into the abyss below. But as increasing numbers of people, particularly young people, awaken to the dangers of inaction on all of these fronts, our desire for long-term self-preservation just might win out in the end. Our future is in our hands, but it will take all of us, working together, to create the one we both desire and require.